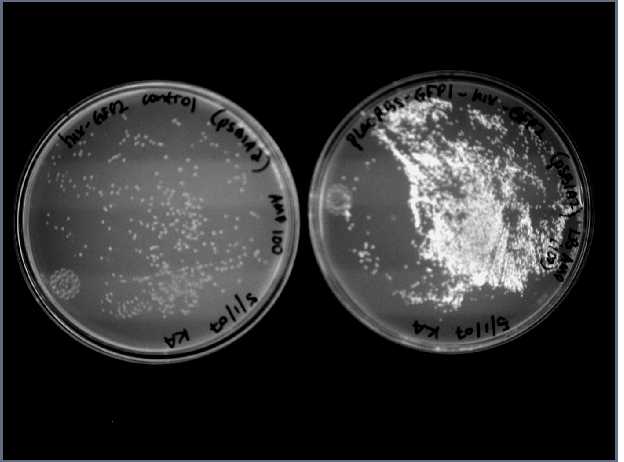

This web page was produced as an assignment for an undergraduate course at Davidson College.
Splitting GFP
Where to insert a HixC site?
Previous studies have inserted short sequences into various regions of GFP without affecting protein function. I chose to insert HixC between amino acids 157 and 158 based on a study that successfully inserted a six-peptide sequence between aa 157 and 158 (Paramban et al, 2004). GFP has a compact cylinder structure consisting of 11 antiparallel β strands and a chromophore buried in the center. The chromophore is the region responsible for GFP fluorescence. Thus, a sequence can be inserted into one of the β barrel loops without affecting GFP function. Check out the interactive chime figure of GFP to see where HixC was inserted.
Mouse-over construct to see HixC sequence and insertion location.


Results
E. coli cells transformed with the GFP construct glow green under UV light (plate on right). The HixC sequence does not interfere with GFP function.